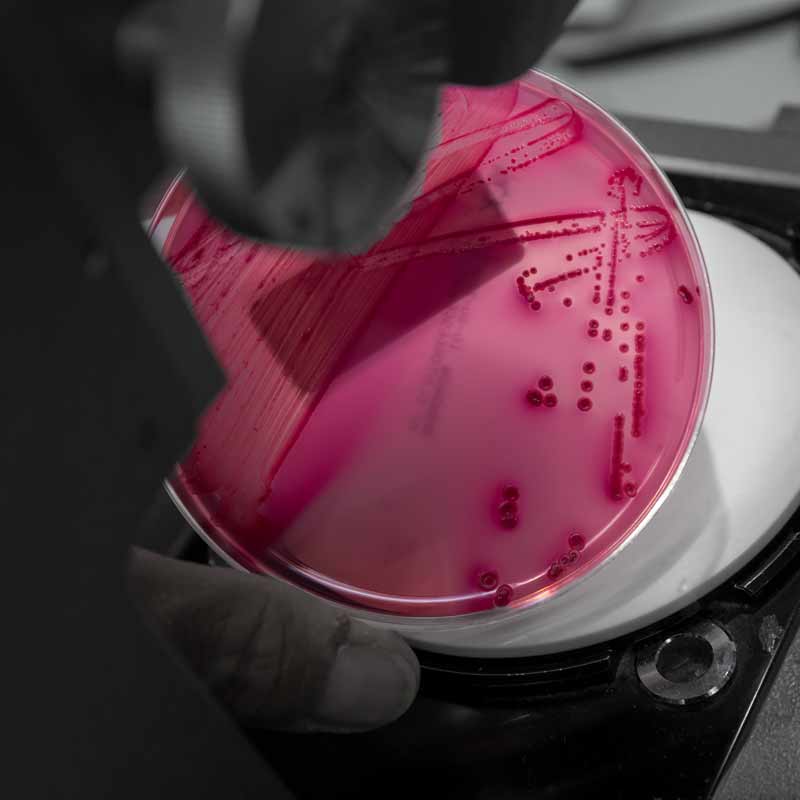

-
 Título oficial
Título oficial
-
240 créditos
-
4 años
-
Presencial
-
Castellano e Inglés
-
Pamplona
-
100 plazas
-
Facultad de Ciencias
Un grado
eminentemente
práctico
La Facultad de Ciencias lleva más de 50 años dedicada a la formación de profesionales de Ciencias. Es la tercera en España en la implantación de los estudios en Biología.
El estudiante del Grado en Biología podrá personalizar su carrera y formarse más intensamente en un área determinada, lo que facilita su inserción en el mundo laboral. Así, podrá adquirir una intensificación en algunas de las áreas más demandadas en el ámbito de la Biología.

Doble Grado único en España
Un doble grado muy completo
En el Doble Grado en Biología y Ciencias Ambientales las bases científicas que aportan las ciencias biológicas se complementan por los conocimientos y las destrezas de las ciencias ambientales, más aplicadas.

Asignaturas en inglés
Carrera profesional e investigadora
El International Science Program prepara a los estudiantes desde primer curso en las competencias necesarias para desenvolverse en un mercado crecientemente global.
Gestión de empresas
Adaptados al mercado laboral
El Science and Business Program te especializará en el ámbito de la empresa científico‐tecnológica.

Diagnóstico biológico
Profundiza en las bases biológicas
En el Diploma in Clinical Biology el alumno adquiere competencias profesionales para una mayor especialización en el campo de los análisis biológicos relacionados con la salud.

Estudio de organismos acuáticos
Estancia en la Universidad de Tromsø
En el Diploma in Marine Biology el alumno enfatiza las adaptaciones fisiológicas y anatómicas de los diferentes hábitats acuáticos.

Diploma
Data Science Program
Este diploma te da competencias profesionales para orientar tu desarrollo profesional en el mundo del análisis y tratamiento de datos. Los estudiantes adquirirán habilidades para extraer conocimiento útil de los datos e interactuar con otros profesionales.

Research Training Program
Más allá de la formación
Los Research Training Program profundizan en áreas como oncología, neurociencia, genética, ciencias cardiovasculares, biología celular y molecular, genética humana...

¿TIENES ALGUNA DUDA?
Escríbenos y trataremos de ayudarte

Puedes preguntarnos lo que quieras, no somos bots, ¿charlamos?

¿Quieres más razones?

Los alumnos del Grado en Biología tienen la posibilidad de participar en un programa de formación específico en inglés que, bajo la supervisión de un tutor, permite, por ejemplo, realizar un proyecto de investigación experimental en Biología dentro del grado, que debe ser preparado y defendido ante un tribunal íntegramente en inglés.
FORMACIÓN COMPLEMENTARIA
Gracias al Science and Business Program podrás completar el Grado con formación en Empresa.
CAMPUS BIOMÉDICO
La Facultad trabaja en estrecha relación con las de Medicina, Enfermería, Farmacia y otros centros de investigación como CIMA (Centro de Investigación Médica Aplicada), CIFA (Centro de Investigación en Farmacobiología Aplicada) y el Centro BIOMA, entre otros.
INTERNACIONALIDAD
Podrás cursar el International Science Program. Significa cursar todo primero, las optativas y el Trabajo Fin de Grado en inglés.

Podrás
trabajar en...
En materias relacionadas con el medio ambiente (gestión y asesoramiento ambiental, control y gestión de la contaminación industrial, agrícola y urbana); con la sanidad (análisis clínicos, bioquímica clínica, microbiología y parasitología); con la industria (gestión de residuos, investigación, desarrollo y control de procesos biológicos industriales, biotecnología)...
FINANCIACIÓN
Que nada te frene hacia tu futuro

Desde los inicios de la Universidad de Navarra hemos trabajado para que ningún estudiante con aptitudes se quede sin cumplir su sueño de estudiar con nosotros por motivos económicos.



Program in Innovation & Entrepreneurship
El primer programa universitario de Emprendimiento que se combina con tu carrera a la perfección









